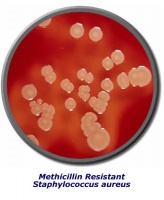
Ученые открыли новый способ воздействия на патогенные бактерии

Найден маркер аутизма?
Большинство случаев данного заболевания остаются недиагностируемыми до 4-х лет, когда становятся очевидными коммуникационные и социальные отклонения. Тем не менее, недавние исследования дают надежду на то, что обнаружение данного синдрома может быть возможно в возрасте 1 года.